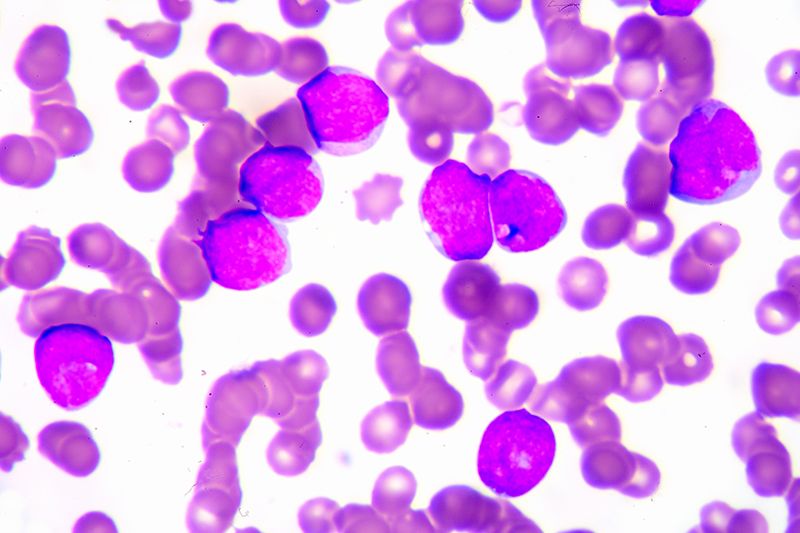
HEMATOLOGIA
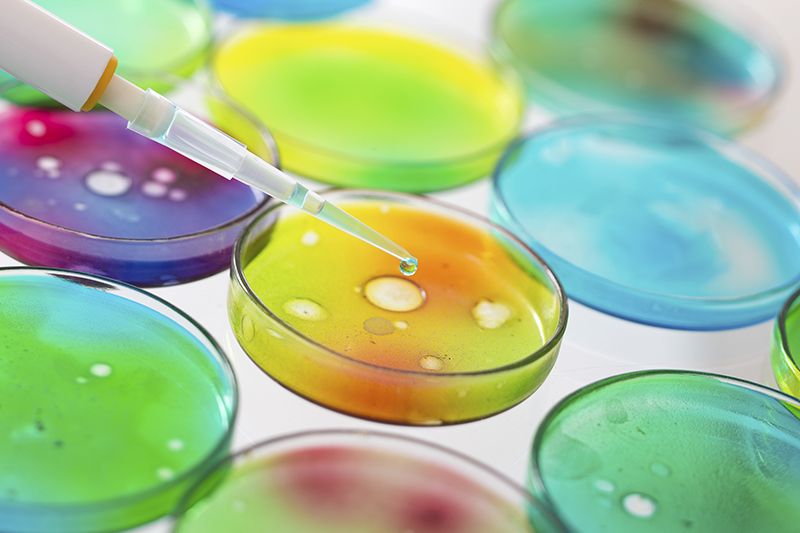
MICROBIOLOGIA - PARASITOLOGIA

SILVERLAB: Nota Informativa
Tota la informació accessible des d'aquest servei WEB pertany a les persones físiques a les quals fa referència cada fragment d'informació a la que es tingui accés.
IMPORTANT!!! Segons el que disposa l'article 19 de la Llei 15/2003, de 18 de desembre, qualificada de Protecció de Dades Personals, les dades relacionades amb la salut de les persones físiques són considerades com a dades sensibles, i per tant només poden ser objecte de tractament o de comunicació amb el consentiment exprés de la persona interessada.
Així, és responsabilitat de cada usuari fer un ús correcte i professional de les dades extretes mitjançant aquest canal de informació. L'usuari és responsable de garantir la confidencialitat de les dades personals objecte de tractament i evitar-ne la divulgació o l’accés no autoritzats. L'Administrador d'Usuaris designat per Bio-Centre ha d'assignar a cada usuari un Nom d'Usuari , el qual és personal i intransferible. Cada usuari serà responsable de la privacitat de la seva contrasenya d'accés, realitzant tants canvis de contrasenya com cregui necessaris per tal d'assegurar la privacitat esmentada.
Ni BIO-CENTRE, com a explotador del sistema, ni DAS, S.L., com a desenvolupador i implantador del sistema, no es faran responsables d'un mal ús de la informació derivat d'un incorrecte ús del sistema per part de l'usuari.
És responsabilitat de BIO-CENTRE realitzar una correcta gestió d'usuaris designant un Administrador d'Usuaris que assigni correctament els permisos a cada usuari que hagi de tenir accés al sistema. També és responsabilitat de BIO-CENTRE realitzar una correcta gestió del sistema, assegurant la màxima seguretat i privacitat en les línies de comunicació per les quals aquest servei és accessible.
BIO-CENTRE, com a explotador del sistema, no es farà responsable d'un mal ús de la informació obtinguda a partir de filtracions de seguretat en les línies de comunicacions i després d'una desencriptació il·legal de la informació.
DAS, S.L., com a desenvolupador i implantador del sistema ofereix un marc de gestió d'usuaris d'acord amb les exigències legals vigents; ofereix un registre il·limitat de totes les activitats de consulta i modificació de les dades accedides mitjançant aquest servei, que és emmagatzemat dins de l'estructura de dades del sistema SilverlabNet i ofereix l'encriptació de totes les comunicacions (configurable).
DAS, S.L, com a desenvolupador i implantador del sistema, no es farà responsable d’un mal ús de la informació obtinguda a partir de filtracions de seguretat en les línies de comunicació en el cas que la informació viatgi desencriptada.
En cas de detectar qualsevol funcionament anòmal del sistema, l'usuari, haurà de notificar el cas a BIO-CENTRE que ho comunicarà al Servei d'Assistència d'Incidències (SAI), per poder avaluar la criticitat i procedir a les accions correctores pertinents.
SILVERLAB: Nota Informativa
Tota la informació accessible des d'aquest servei WEB pertany a les persones físiques a les quals fa referència cada fragment d'informació a la que es tingui accés.
IMPORTANT!!! Segons el que disposa l'article 19 de la Llei 15/2003, de 18 de desembre, qualificada de Protecció de Dades Personals, les dades relacionades amb la salut de les persones físiques són considerades com a dades sensibles, i per tant només poden ser objecte de tractament o de comunicació amb el consentiment exprés de la persona interessada.
Així, és responsabilitat de cada usuari fer un ús correcte i professional de les dades extretes mitjançant aquest canal de informació. L'usuari és responsable de garantir la confidencialitat de les dades personals objecte de tractament i evitar-ne la divulgació o l’accés no autoritzats. L'Administrador d'Usuaris designat per Bio-Centre ha d'assignar a cada usuari un Nom d'Usuari , el qual és personal i intransferible. Cada usuari serà responsable de la privacitat de la seva contrasenya d'accés, realitzant tants canvis de contrasenya com cregui necessaris per tal d'assegurar la privacitat esmentada.
Ni BIO-CENTRE, com a explotador del sistema, ni DAS, S.L., com a desenvolupador i implantador del sistema, no es faran responsables d'un mal ús de la informació derivat d'un incorrecte ús del sistema per part de l'usuari.
És responsabilitat de BIO-CENTRE realitzar una correcta gestió d'usuaris designant un Administrador d'Usuaris que assigni correctament els permisos a cada usuari que hagi de tenir accés al sistema. També és responsabilitat de BIO-CENTRE realitzar una correcta gestió del sistema, assegurant la màxima seguretat i privacitat en les línies de comunicació per les quals aquest servei és accessible.
BIO-CENTRE, com a explotador del sistema, no es farà responsable d'un mal ús de la informació obtinguda a partir de filtracions de seguretat en les línies de comunicacions i després d'una desencriptació il·legal de la informació.
DAS, S.L., com a desenvolupador i implantador del sistema ofereix un marc de gestió d'usuaris d'acord amb les exigències legals vigents; ofereix un registre il·limitat de totes les activitats de consulta i modificació de les dades accedides mitjançant aquest servei, que és emmagatzemat dins de l'estructura de dades del sistema SilverlabNet i ofereix l'encriptació de totes les comunicacions (configurable).
DAS, S.L, com a desenvolupador i implantador del sistema, no es farà responsable d’un mal ús de la informació obtinguda a partir de filtracions de seguretat en les línies de comunicació en el cas que la informació viatgi desencriptada.
En cas de detectar qualsevol funcionament anòmal del sistema, l'usuari, haurà de notificar el cas a BIO-CENTRE que ho comunicarà al Servei d'Assistència d'Incidències (SAI), per poder avaluar la criticitat i procedir a les accions correctores pertinents.
 Àrea Usuaris
Àrea Usuaris Àrea Professionals
Àrea Professionals